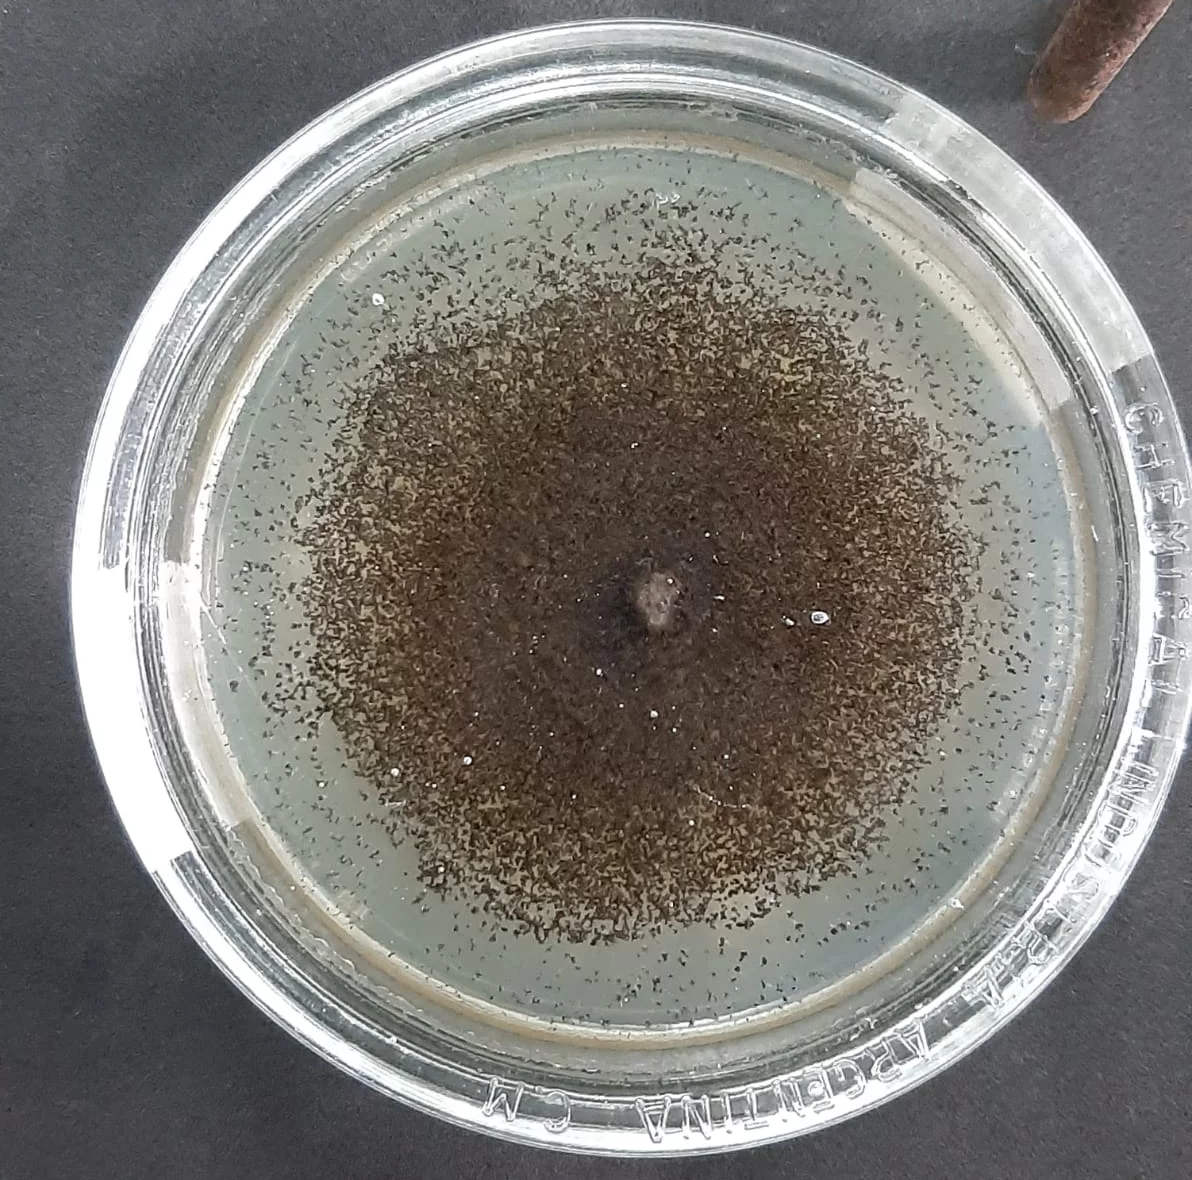

Biocombustibles
El objetivo del proyecto es utilizar el bagazo de caña de azúcar, residuo en la extracción de azúcar, para producir bioetanol, a partir de la sacarificación y fermentación simultánea, empleando enzimas producidas por hongos aislados en Misiones. Se propone utilizar Aspergillus niger perteneciente al cepario del Laboratorio de Biotecnología Molecular (LBM) del Instituto de Biotecnología Misiones (InBioMis). Como resultado principal del proyecto se espera obtener bioetanol a partir de residuos de las agroindustrias azucarera y almidoneras regionales. Este resultado implica utilizar desechos como materia prima en una nueva línea de proceso. El proceso será biotecnológico, lo que conlleva utilizar menos reactivos químicos y catalizadores biodegradables (enzimas). Reducir los costos es un desafío al buscar implementar una nueva línea de proceso, es por ello que las enzimas a utilizar serán producidas por un hongo aislado de la provincia de Misiones, del cual ya se conoce que produce elevada actividad enzimática, y se conoce además las condiciones óptimas de producción de estas enzimas y sus óptimas condiciones operativas.
Integrantes
Investigadores
- Maria Daniela Rodriguez
Becarios
- Gabriela Verónica Díaz
- Romina Olga Coniglio
- Laura Ester Ortellado
- Teresa Genara Espinosa
- Ivan Marmilich
- Miguel Nicolas
Proyectos
“Producción misionera de bioetanol a partir de residuos agroindustriales regionales” MI-02 / PFI-2021
Objetivo general : utilizar residuos de las agroindustrias misioneras, bagazo de caña de azúcar y bagazo de mandioca, para producir bioetanol empleando enzimas producidas por hongos aislados en Misiones.
Objetivos específicos :
1) Producir enzimas a partir de Aspergillus niger LBM 134.
2) Pretratar los bagazos.
3) Sacarificar y fermentar simultáneamente los bagazos.
4) Cuantificar el bioetanol obtenido y estimar rendimientos del proceso
5) Transferir y capacitar
Publicaciones
Gil, M. F., Fassolari, M., Battaglia, M. E., & Berón, C. M. (2021). Culex quinquefasciatus larvae development arrested when fed on Neochloris aquatica. PLOS Neglected Tropical Diseases, 15(12), e0009988. https://doi.org/10.1371/journal.pntd.0009988
Castrillo, M. L., Bich, G. Ángel, Amerio, N. S., Rodriguez, M. D., Zapata, P. D., & Villalba, L. L. (2021). Assessment of cellulase complex secretory capacity of Trichoderma strains and morphological and molecular identification of the isolate with the highest enzymatic secretion capacity. Journal of Microbiology, Biotechnology and Food Sciences, 10(5), e1357. https://doi.org/10.15414/jmbfs.1357
Rodríguez, M. D., Alonso Paiva, I. M., Castrillo, M. L., Zapata, P. D. & Villalba, L. L. (2019). KH2PO4 improves cellulase production of Irpex lacteus and Pycnoporus sanguineus. Journal of King Saud University - Science, 31 (4), 434-444. https://doi.org/10.1016/j.jksus.2018.07.009.
Prigioni, G. A., Rodríguez, M. D., Zapata, P. D. & Villalba, L. L. (2018). Licor de maíz como medio de cultivo para la producción de lacasa por Phlebia brevispora. Revista de Ciencia y Tecnología, 20 (30), 21-26. https://www.fceqyn.unam.edu.ar/recyt/index.php/recyt/article/view/217
Rodríguez, M. D., Castrillo, M. L., Velázquez, J. E., Kramer, G. R., Sedler, C., Zapata, P. D., & Villalba, L. (2017). Obtención de azúcares fermentables a partir de aserrín de pino pretratado secuencialmente con ácido-base. Revista Internacional De Contaminación Ambiental, 33(2), 317–324. https://doi.org/10.20937/RICA.2017.33.02.12